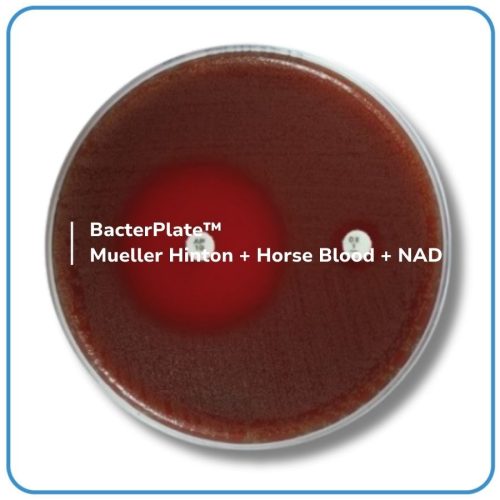

BacterPlate™ Mueller Hinton + Horse Blood + NAD (MHF)
Mã: 05029
Mã đặt hàng/sản phẩm: 4102016
Số lượng tối thiểu: 1
Qui cách đóng gói:
10 đĩa/hộp
- BacterPlate™ Mueller Hinton + Horse Blood + NAD (MHF) là môi trường sẵn sàng sử dụng, được thiết kế để kiểm tra độ nhạy kháng sinh bằng phương pháp khuếch tán đĩa. Bao gói bằng màng bán thấm Cellophane film giúp cân bằng độ ẩm môi trường trong quá trình bảo quản.
- Thành phần trong 1L môi trường (tham khảo): Acid Digest of Casein; Meat Extract; Soluble starch; Defibrinized horse blood; NAD; Agar. pH của môi trường hoàn chỉnh ở 25°C: 7,4 ± 0,2.
- Quy cách: 10 đĩa/ hộp hoặc theo yêu cầu của khách hàng.
- Bảo quản lưu trữ: 2 – 8°C.
- Vận chuyển: Nhiệt độ môi trường.
- Hạn sử dụng: 04 tháng kể từ ngày sản xuất.
Danh sách đặt hàng
BacterPlate™ Mueller Hinton + Horse Blood + NAD (MHF)
Mã: 4102016
Đơn vị: Đĩa
| Tên sản phẩm | Hình ảnh | Mã đặt hàng/sản phẩm | Đơn vị tính | Số lượng | Chọn vào giỏ hàng |
|---|---|---|---|---|---|
| BacterPlate™ Mueller Hinton + Horse Blood + NAD (MHF) | ![]() | 4102016 | Đĩa |
